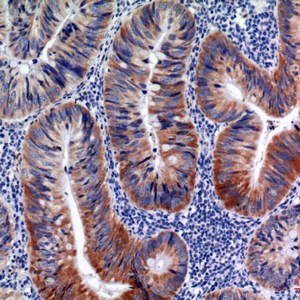
AID Polyclonal Antibody

CD4 Monoclonal Antibody (11A1)
Clonality: Monoclonal
Host: Mouse
Reactivity: Human, Mouse, Rat
Application: IHC-p, IF, ICC
Storage: -20°C for 1 year
Conjugation with Bright-Dtech™ on request
![]()
Description
Data sheet CD4 Monoclonal Antibody (11A1)
Background: This gene encodes a membrane glycoprotein of T lymphocytes that interacts with major histocompatibility complex class II antigenes and is also a receptor for the human immunodeficiency virus. This gene is expressed not only in T lymphocytes, but also in B cells, macrophages, and granulocytes. It is also expressed in specific regions of the brain. The protein functions to initiate or augment the early phase of T-cell activation, and may function as an important mediator of indirect neuronal damage in infectious and immune-mediated diseases of the central nervous system. Multiple alternatively spliced transcript variants encoding different isoforms have been identified in this gene.
Purification:Affinity-purified from mouse ascites by affinity-chromatography using specific immunogen.
Concentration: 1 mg/ml
Formulation: PBS, pH 7.4, containing 0.5%BSA, 0.02% sodium azide as Preservative and 50% Glycerol.
Molecular weight: 51111
Gene ID: Human: 920; Mouse: 12504; Rat: 24932
Synonyms:CD4; T-cell surface glycoprotein CD4; T-cell surface antigen T4; Leu-3; CD4
Research area:Immunology; Stem cells
Target protein: CD4
Additional information
| Weight | 0.7 kg |
|---|---|
| Dimensions | 14 × 15 × 11 cm |
| Size | 20 μL, 50 μL, 100 μL |